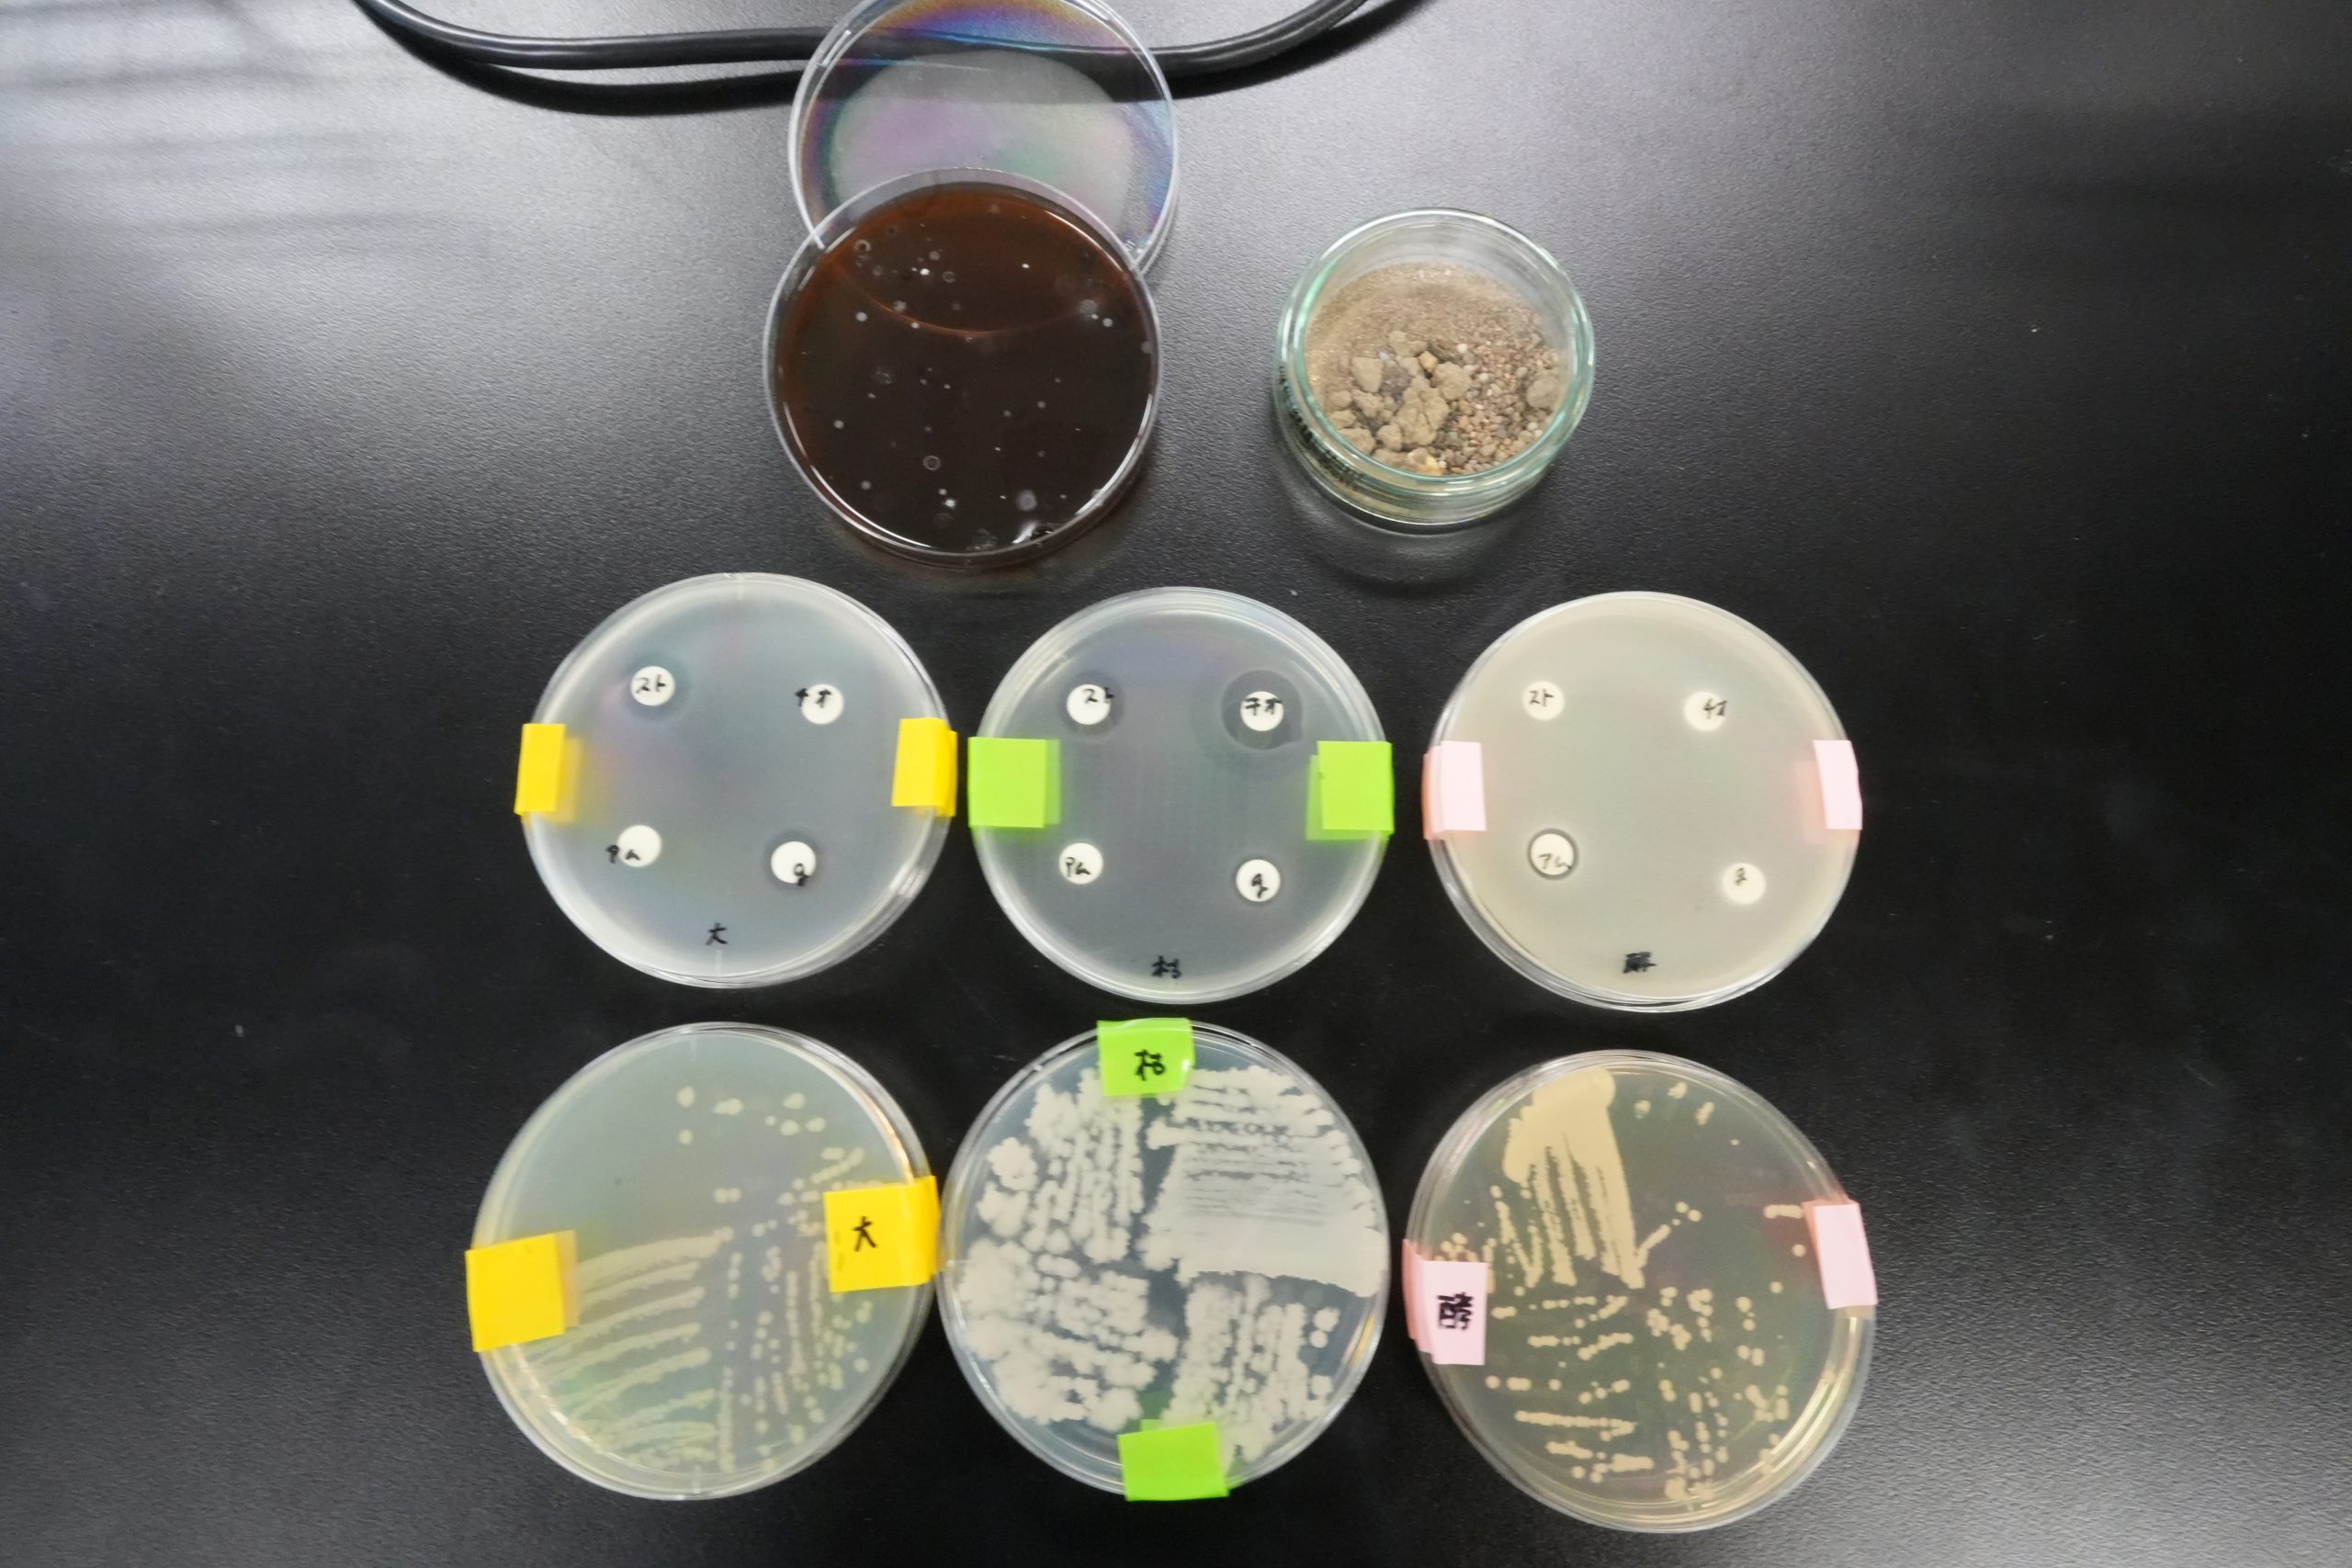

08/03/2025
今年も福井県立大学オープンキャンパス2025が開催されました。
午前と午後の2回の開催で、それぞれ100名近くの皆さんがご参加くださいました!
当研究室からは、学部4年生と博士前期課程1年の学生が研究紹介を担当しました。
土壌から放線菌を分離する方法や、放線菌が作り出す生理活性物質の探索方法、抗生物質とは?など、盛り沢山な内容で、参加者してくれた高校生や親御さん方も大変興味を持って聞いてくださいました!
たくさんのご参加、誠にありがとうございました!